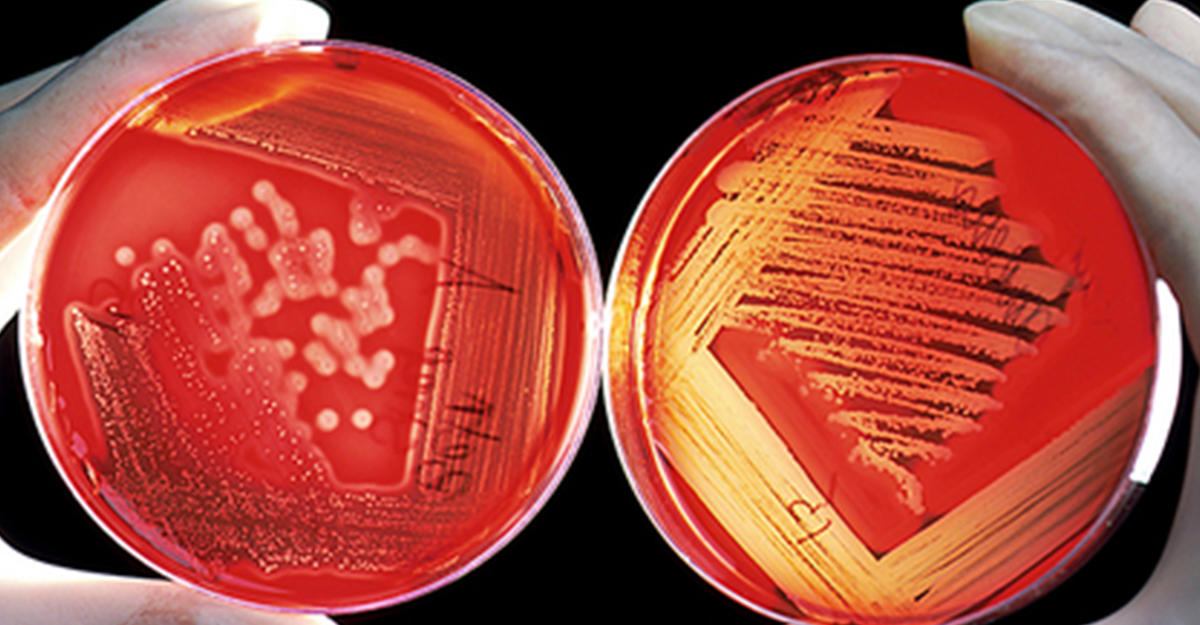

Найдено эффективное средство против смертоносного рака
Исследователи из Университета Кардиффа разработали способ поиска и уничтожения аномальных T-клеток, которые способствуют возникновению крайне агрессивной формы рака крови - T-клеточной лимфомы.
Исследователи из Университета Кардиффа разработали способ поиска и уничтожения аномальных T-клеток, которые способствуют возникновению крайне агрессивной формы рака крови - T-клеточной лимфомы. Метод основан на выявлении только тех клеток, которые имеют на мембране специфичный рецептор, при этом побочное воздействие на иммунную систему снижено до минимума.
Лимфомы образуются при бесконтрольном делении злокачественных иммунных клеток (Т-лимфоцитов). Для лечения опухолей необходимо найти такой способ уничтожения дефектных клеток, чтобы здоровые Т-лимфоциты при этом остались нетронутыми.
Новый метод основан на избирательном действии препаратов, которые находят и убивают только те клетки, что несут один из двух клеточных рецепторов, характерный для опухоли. Каждая Т-клетка имеет либо рецептор C1, либо рецептор C2. Когда клетка перерождается в злокачественную и дает начало раку, все дефектные клетки несут только один тип рецептора, например, С1.
Препараты на основе антител, специфичных к такому рецептору, могут уничтожать все клетки, имеющие C1, но оставлять Т-лимфоциты, несущие C2. Таким образом, у пациента продолжает функционировать иммунная система, защищая его от различных инфекций.
Присоединяйтесь к нашей Facebook странице и читайте интересные материалы каждый день
















.jpg)